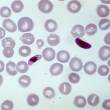

Diagnostics 
Quicker, low-cost breast cancer diagnosis
(0)Doctors at the Netaji Subhash Chandra Bose Government Medical College and Hospital, Jabalpur have come up with technique to diagnose breast cancer even in remote health centres. All you need is a syringe available even in resource poor clinics and a microscope. Sanghamitra reports from Cuttack.
Fibre biosensor to diagnose cardiovascular disease
The amount of the proteins, troponin T and troponin I, in blood is helpful to assess the damage done due to a heart attack. Troponin I is a better indicator. Researchers have now come up with a lab-on-a-chip device to detect the protein. Read the details of their ingenious invention.

Tears as Clues: Towards global research standards
Tears hold clues about infections or inflammation of the eyes. Research suggests that tears may also have biomarkers to help detect many other conditions, including cancer and neurodegeneration. Here is a report on removing the main roadblock in research and development in this direction.
Malignant Melanomas in India
Melanoma patients in India have a pattern of mutations that is different from the pattern seen worldwide, say researchers from the Homi Bhabha National Institute. While 75% of the patients in global sample have mutations in two genes, Indians cases have only 31%. A Anuradha reports.
Detecting Ovarian Cancer
Researchers from IIT Hyderabad and IIT Bombay collaborated to come up with a method to detect ovarian cancer. They attached antibodies against fibronectin, a protein, to porous carbon derived from sweet corn husk to make the biosensor.
Spontaneous Abortions: Chlamydia and microRNAs
Infection by Chlamydia trachomatis, a bacteria, can cause recurrent spontaneous abortions. Sangita Rastogi and team, ICMR-NIP, New Delhi recently identified two biomarkers in urine that signal the possibility of spontaneous abortion. Read on for details.
Speech Signals: biomarkers for heart failure
Madhu Keerthana from IIT Kharagpur and collaborators from Finland have come up with an automated system to identify heart problems from speech signals of patients. A medical technology in the making.
Circular RNAs as Colorectal Cancer Biomarkers
Rajabrata Bhuyan from the Banasthali Vidyapith and Angshuman Bagchi from the University of Kalyani have identified circular non-coding RNAs involved in colorectal cancers. This type of RNAs may one day become a part of cancer diagnostics and perhaps will even play a role in therapeutics.
Photonic Crystal to Diagnose Malaria
Diagnosing malaria is difficult because there are different Plasmodium species producing wide variations in symptoms. And blood smear test often gives false negatives. Researchers from three colleges in Bikaner have now come up with a new faster and more accurate, diagnostic tool.
Sensing Hydrogen Sulphide
Hydrogen sulphide, toxic at high concentrations, is an important part of out physiology at very low concentrations. A sensor that is sensitive enough to detect the changes in its concentrations are important in the diagnosis of many diseases. Indian researchers have now found a way, using the chromophore of a fluorescent protein.
